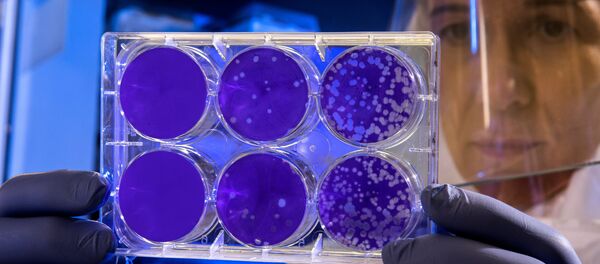

АҞӘА, мшаԥы 7– Sputnik, Бадри Есиава. Аҟәатәи амедицинатә коллеџь астудентцәа ԥшьҩык мчыбжьык иназынаԥшуа Ареспубликатә хәыҷтәы хәышәтәырҭаҿы асааҭ 9:30 - 17:00 рзы иҷаԥшьоит ҳәа Sputnik иазеиҭалҳәеит аколлеџь адиректор Нато Ҭарба.
"Аҟәа инхо, астоматологиа афакультет аҿы аҵара зҵо ҳастудентцәа ԥшьҩык мчыбжьык иназынаԥшуа Ареспубликатә хәыҷтәы хәышәтәырҭаҿы иҷаԥшьоит", - лҳәоит адиректор.
Урҭ руаӡәк, Милена Геврекиди илҳәеит, ахәыҷтәы хәышәтәырҭаҿы ацхыраара шалшо шеилылкааз WhatsApp аҿтәи акурс ачат аҿы.
"Аԥхьатәи амш азыҵәҟьа ҳаиқәдыршәеит: ахалаҭқәа, асабрадақәа, анапҭарԥақәа ҳарҭеит. Ҳара адкыларатә ҟәшаҿы ҳҷаԥшьоит. Чмазаҩбара ҳәа аӡәы дааир доуҳашьҭуам, ус џьара ак рыҭатәызар ираҳҭоит. Арахь иааиз ашоура рымазар, аихшарҭатә ҭыԥ ахь инаҳашьҭуеит", - еиҭалҳәоит Геврекиди.
Лара ишылҳәаз ала, ахәышәтәырҭа аҳақьымцәа рнапынҵақәа зеиԥшраз рзеиҭарҳәеит, идеилдыркааит рхымҩаԥгашьа шеиҿкаатәу, иара убасгьы акоронавирустә инфекциа аҟазшьақәа ртәы рзеиҭарҳәеит.
Астудент Ахра Багаҭелиагьы ахәыҷтәы хәышәтәырҭаҿы волонтиорс дыҟоуп. Иара иажәақәа рыла, аҵаратә процесс аанкылоуп азы аамҭа рацәаны имоуп.
Аҟәатәи амедицинатә коллеџь астудентцәа Ареспубликатә хәыҷтәы хәышәтәырҭаҿы асааҭ 9:30 - 17:00 рзы иҷаԥшьоит.
Акоронавирус иадҳәалоу аҵыхәтәантәи ажәабжьқәа шәрыԥхьар ҟалоит абра>>